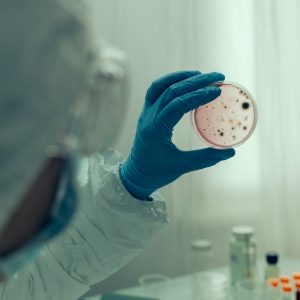
Virus

La provincia de Sevilla es una de las más afectadas en los últimos días, pues la Junta de Andalucía confirmado nueve casos de Virus del Nilo Occidental (VNO) en este lugar. Una cifra que ha asustado a muchos ya que entre el 1 de enero y el 2 de agosto de este año se habían contado 17 casos.
Los casos confirmados han preocupado a los municipios donde hay afectados. Estos son: Dos Hermanas (3 casos), Coria del Río (4), Lebrija (1), Los Palacios y Villafranca (4), Tomares (1) y La Puebla del Río (4), según confirma el Ministerio de Sanidad y la Junta de Andalucía.
La viróloga y catedrática en el departamento de Genética y Microbiología de la Universidad de Barcelona, Silvia Bofill, ha explicado a EFE que la mayoría de las infecciones por el virus del Nilo son asintomáticas y en muy pocos casos, menos del 1 %, se manifiesta con enfermedad neuroinvasiva. Puedes experimentar episodios de fiebre.
El virus del Nilo es el causante de la enfermedad conocida como fiebre del Nilo y es una afección que se transmite por la picadura de mosquitos infectados. Estos mosquitos la contraen a través de picar a los pájaros que son portadores.
Tal como ha recalcado la Consejería de Salud andaluza, el virus se transmite entre las aves a través de la picadura de mosquitos infectados siendo éste su ciclo natural, mientras que los humanos y otros mamíferos pueden infectarse de forma colateral, sin que desde ellos se produzcan nuevas transmisiones.